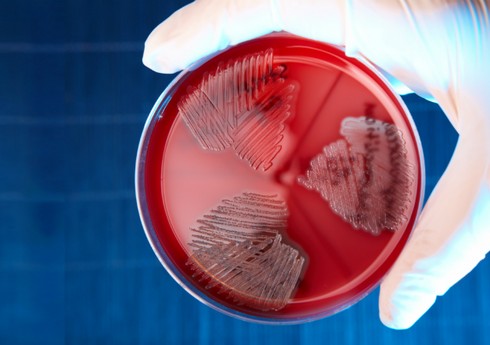
В Гонконге стрептококковой инфекцией заразились минимум 27 человек

В Гонконге стрептококковой инфекцией заразились минимум 27 человек
Вспышка вызываемой стрептококками группы B (Streptococcus agalactiae) инфекции зафиксирована в Гонконге в последние несколько недель.
Как передает со ссылкой на газету South China Morning Post, в общей сложности было выявлено 27 случаев заражения, 2 из которых закончились летальным исходом.
По ее данным, в августе и начале сентября был зафиксирован значительный рост заболеваемости. Среди заболевших 10 мужчин и 17 женщин в возрасте от 53 до 88 лет. У них наблюдается штамм ST283, источником распространения которого считается пресноводная рыба.
Как отмечает газета, пять зараженных уже выписаны из медучреждений. 17 пациентов находятся в стабильном состоянии, еще трое в тяжелом, а двое умерли. У больных наблюдаются типичные для такой инфекции симптомы: сепсис, абсцесс суставов, менингит, а также воспаление мочевыводящих путей.
Очаг распространения инфекции не был найден, но 90% инфицированных указали, что незадолго до заражения контактировали с сырой пресноводной рыбой. При этом 19 пациентов посещали отделы с живой рыбой на 14 разных рынках города.
Эпидемиологи призвали жителей временно воздержаться от употребления в пищу сырой пресноводной рыбы, а также не чистить ее, если на руках есть открытые раны.
Похожие новости
В Гонконге распространилась стрептококковая инфекция, есть умершие
Вирус оспы обезьян: как он распространяется, может ли вызвать такую же пандемию, как COVID?
China Energy: Экспорт зеленого водорода и аммиака создаст значительные возможности для Азербайджана
ВОЗ: Нет необходимости в закрытии, как в ситуации с COVID-19
Представитель США посетит КНР для обсуждения санкций за торговлю с РФ
Президент Азербайджана выступил на Международном форуме Черноббио - ОБНОВЛЕНО-1
На Филиппинах сообщили о новых случаях заражения оспой обезьян
Коммерческий директор AZAL: Цена билета не всегда зависит от желания авиакомпании- ИНТЕРВЬЮ
Число заболевших оспой обезьян в Африке с начала года достигло 22,8 тыс.
При захвате заложников в ИК в Волгограде погибли четверо сотрудников ФСИН РФ - ОБНОВЛЕНО-6 - ФОТО - ВИДЕО
В Канаде отметили рост заболеваемости детей коклюшем
Президенты Азербайджана и Узбекистана выступили с заявлениями для прессы - ОБНОВЛЕНО + ФОТО
Последние новости у нас
Следите за нами на странице Facebook
Другие новости
-
Зелим Цкаев вышел в полуфинал чемпионата Европы в Тбилиси
-
Джейхун Байрамов встретился с министром иностранных дел Гвинеи-Бисау
-
Обсуждена повестка сотрудничества между Азербайджаном и Алжиром
-
Мехрибан Алиева в Анталье приняла участие в панели в рамках Анталийского дипломатического форума
-
Официальный Тегеран высоко ценит поддержку и солидарность Азербайджана с Ираном
-
Азербайджанский дзюдоист Зелим Цкаев завоевал бронзу на чемпионате Европы













